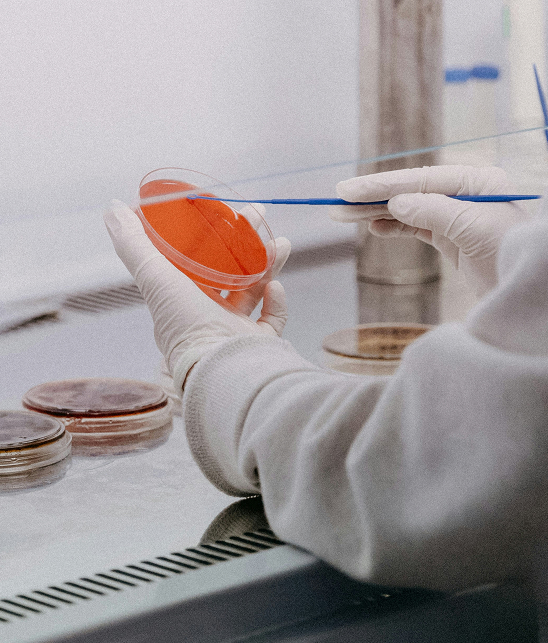

Building A
Better Tomorrow
We offer solutions in distribution, supply, and retail, ensuring our products are reliably sourced and meet the highest standards.






















Our Journey
1999

The journey of KMM begins.
2000

Began exporting KARA coconut milk powder to China, Hong Kong, and Taiwan
2003

Started exporting desiccated coconut (commodity products) to the Middle East, China, Bangladesh, and Pakistan
2008
Took up the first food agency brand, diversifying from the coconut-related business
2012

Obtained ISO 9001:2008 and ISO 14001:2004 certifications
Launched KARTA brand
New Dedicated Line TBA for Kara Coconut Cream (Extract) 200ml
2013

Launched AKASA brand
2014


First sailing of our own tongkang - KARTA SAKTI
Opening of warehouse in Puncak Alam (with 30,725 sq. ft. and 2238 pallet positions)
2016


Won the Indonesia Prima Duta Award
Won the Top 20 Business Excellent Awards
2017

Won the Prima Duta Award for the second year
Recertification ISO 9001:2015 and ISO 14001:2015
Became the sole distributor for the first halal-certified skincare and beauty cosmetic brand in Malaysia
2020

Launched the e-commerce platform Karta Supermall
2021

Relocated the warehouse to the U10 Shah Alam Distribution Centre (with 121,925 sq. ft. and 12,102 pallet positions)
2023

Opening of regional hub Distribution Centre in Johor (with 55, 219 sq. ft. and 1968 pallet positions)
2024





Expanded Karta product range into fruit juice drink (KARTA FRUTA)
Launched the new 110ml pack size for Kara Coconut Cream (Extract)
Won the Indonesia Prima Duta Award
Completed the first sailing of our own barge - Karta Marine 88 and also own container - 205 unis
Celebrated our 25th anniversary
Winner of the Kancil Award (Kara Brand)
2025

25th Anniversary Dinner Night
QC Check Laboratory
KMM applies rigorous tests on all its food products to ensure they are of the highest quality and safety at ALL times. KMM employs a dedicated team of workers who meticulously and laboriously examine each product at the laboratory, which has two laboratories – the Physico-Chemical Lab and Microbiological Lab.

Physico-Chemical Lab Test Parameters
- Fat content
- Brix
- pH
- Moisture

Microbiological Lab Test Parameters
- Total Plate Count
- E.Coli
- Staphylococcus aureus
- Salmonella
- Enterobacteriaceae
- Yeast and mould
R&D Kitchen
As a testament to its commitment to the highest quality control standard, KMM has invested heavily in laboratory facilities for lab scale blending, food application test and sensory evaluation for specialised food ingredients.

Lab scale blending
For new product development or product enhancement. For example, small lab scale blending of different flavours for coconut water can be conducted.

Food application test
Consumer taste and trend keep changing. To ensure KMM products match the changing consumer taste and remain the top consumer choice, food applications tests are continually conducted on KMM brands and other brands.
Sensory evaluation
Sensory evaluation helps to fine-tune the results from lab scale blending and food application test to obtain the exact formulation that will make KMM products the consumers’ first choice.
Certified for Quality

ISO 9001:2015 Quality Management System (Standards Malaysia and UKAS Standard)

ISO 14001:2015 Environment Management System (Standards Malaysia and UKAS Standard)
Member of SEDEX (Supplier Ethical Data Exchange)

Product Certified Halal by JAKIM (Malaysia)

Product Certified Halal by MUI (Indonesia)

Product Certified Kosher














